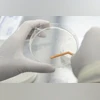
17-year old dies in Guwahati, first suspected case of GBS in Assam Disease X

A 17-year-old girl died at a private hospital here due to suspected Guillain-Barre Syndrome (GBS), the first such case in Assam in the current season, doctors of the health facility said on Saturday.
However, there was no official confirmation from the hospital and the state health department.
"The Class-12 girl was admitted to Pratiksha Hospital around 10 days ago and she was diagnosed with GBS," a paediatrician of the hospital told PTI on condition of anonymity.
GBS is a rare condition that causes sudden numbness and muscle weakness, with symptoms including severe weakness in the limbs and loose motions.
"The girl's condition worsened and was put on ventilator support. It was a very severe variety of GBS and she expired last night," the doctor said.
He said it is the "first known case of GBS in Assam" this season, although it is a very common bacterial disease, affecting the nervous system.
"In the last six months, no GBS case was detected. All over India, there has been a wave of GBS cases right now and it is detected in many places.
"The symptoms of the deceased were similar to those diagnosed with GBS in other parts of the country like Maharashtra, South India and West Bengal. We are fearing that there may be more such cases in the coming days," he said.
The girl hailed from Bihar and was living in Assam.
"The parents wanted to take her to Delhi for advanced treatment and an air ambulance was also arranged for. However, she could not survive and died last night," a colleague of the girl's father said.
A senior paediatrician surgeon, who did not wish to reveal his name, told PTI that GBS cases are detected every year throughout the state and it is not very severe usually.
"Though some patients get paralysed due to GBS, they recover with proper medication. They may not be fully normal but they can do their daily routine work on their own. So, there is no need to create any panic for GBS," he added.
(Only the headline and picture of this report may have been reworked by the Business Standard staff; the rest of the content is auto-generated from a syndicated feed.)
You’ve reached your limit of {{free_limit}} free articles this month.
Subscribe now for unlimited access.
Already subscribed? Log in
Subscribe to read the full story →
Smart Quarterly
₹900
3 Months
₹300/Month
Smart Essential
₹2,700
1 Year
₹225/Month
Super Saver
₹3,900
2 Years
₹162/Month
Renews automatically, cancel anytime
Here’s what’s included in our digital subscription plans
Exclusive premium stories online
Over 30 premium stories daily, handpicked by our editors


Complimentary Access to The New York Times
News, Games, Cooking, Audio, Wirecutter & The Athletic
Business Standard Epaper
Digital replica of our daily newspaper — with options to read, save, and share


Curated Newsletters
Insights on markets, finance, politics, tech, and more delivered to your inbox
Market Analysis & Investment Insights
In-depth market analysis & insights with access to The Smart Investor


Archives
Repository of articles and publications dating back to 1997
Ad-free Reading
Uninterrupted reading experience with no advertisements


Seamless Access Across All Devices
Access Business Standard across devices — mobile, tablet, or PC, via web or app
)